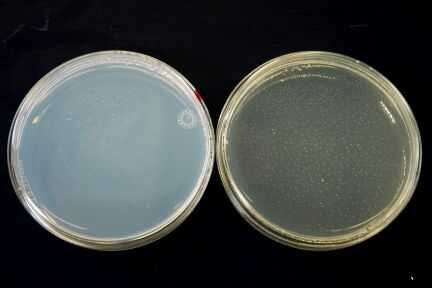

Paso 3: Preparación de Agar y placas
Si, por cualquier razón no les importa usar placas preparadas puede hacer placas de agar de tableta, en polvo o embotellada agar siguiendo unas sencillas instrucciones.
Agar puede obtenerse en tiendas naturistas y supermercados de alta gama con departamentos de alimentos. Los empleados serán capaces de ayudarle si usted pregunta si llevan ' el suplemento dietético agar y calcio suplementos con carbonato de calcio ya que un amigo les recomendó "en cambio"Hey, chicos tenes cualquier cosas para criar algas?"
Mantenga los platos Petri u otros recipientes de cultivo limpio (estéril) y cerrado hasta justo antes del uso. Levantar la tapa lo menos posible al llenar los recipientes y tapa inmediatamente para evitar la contaminación.
Preparación de la tableta o en polvo de Agar:
Disolver 1 bar, 10 pastillas o 7 gramos de agar en polvo en 1/2 cuarto de galón de suelo-agua que preparado en el último paso. Caliente el agar en un baño de agua caliente colocando en un frasco de vidrio. Calentar el agua en la estufa hasta que casi hierva, retirar del fuego y coloque el frasco de agar en el agua. El microondas es otra buena forma. Simplemente calentar un recipiente con agua y coloque el frasco con el agar en el centro.
Como calienta el agar comenzará a derretir, calentar el agar hasta que se convierte en líquido. Retire del fuego y dejamos que se enfríe un poco. Añadimos 7 gotas de abono líquido de Schultz y mezclar bien para distribuir el alimento uniformemente en todo el agar.
Vierta suficiente del líquido en cada recipiente para cubrir el fondo de aproximadamente 1/8 de pulgada y colocar en un contador que se enfríe. El agar se establecerá como una gelatina rígida a temperatura ambiente.
Si el agar no configurada correctamente pruebe con agar más. Agar extra puede almacenar y volver a licuado en un baño de agua caliente. Mantener las muestras cubiertas y tenga cuidado para evitar la contaminación.
Almacenamiento: Apilar las placas de agar hacia abajo en el refrigerador. No lo congele! El propósito de colocar las placas boca abajo es evitar la condensación de goteo hacia abajo sobre la superficie del agar que luego podría facilitar el movimiento de organismos entre las colonias.
Para aquellos que quieren más rígidamente controlados independiente trabajan la formulación de LB (agar nutritivo de uso general de Luria Bertani) es: 9,1 G/l triptona, 4,6 g/L levadura extracto, 4,6 g/L de NaCl y agar de 13,7 g/L. se vierten 500 ml de agar ~ 25 grandes placas de Petri (100 mm de diámetro) o platos de Petri pequeña 50 (ø 60 mm).
A continuación vamos a construir una incubadora para el cultivo de algas. Es un lugar cálido y seguro para las algas crecer en condiciones controladas como la población es criada.